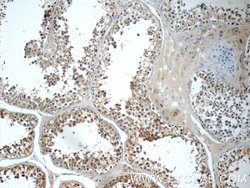
AP2A2 Rabbit anti-Human, Mouse, Rat, Polyclonal, Proteintech:Anticuerpos:Anticuerpos

missing translation for 'onlineSavingsMsg'
Learn More
Learn More
AP2A2 Rabbit anti-Human, Mouse, Rat, Polyclonal, Proteintech
Rabbit Polyclonal Antibody
145.00€ - 410.00€
Especificaciones
| Antígeno | AP2A2 |
|---|---|
| Concentración | 0.27 mg/mL |
| Aplicaciones | Western Blot, Immunohistochemistry (Paraffin) |
| Clasificación | Polyclonal |
| Conjugado | Unconjugated |
| Código de producto | Marca | Cantidad | Precio | Cantidad y disponibilidad | |||||
|---|---|---|---|---|---|---|---|---|---|
| Código de producto | Marca | Cantidad | Precio | Cantidad y disponibilidad | |||||
|
16895024
|
Proteintech
15722-1-AP-20UL |
20 μL |
145.00€
20 microlitros |
Por favor, inicie sesión para comprar este producto. ¿No tiene usuario web? Regístrese hoy mismo. | |||||
|
16885024
|
Proteintech
15722-1-AP-150UL |
150 μL |
410.00€
150 microlitros |
Por favor, inicie sesión para comprar este producto. ¿No tiene usuario web? Regístrese hoy mismo. | |||||
Descripción
Adaptins are components of the adaptor complexes which link clathrin to receptors in coated vesicles. Clathrin-associated protein complexes are believed to interact with the cytoplasmic tails of membrane proteins, leading to their selection and concentration. Alpha adaptin is a subunit of the plasma membrane adaptor. It binds polyphosphoinositides.Especificaciones
| AP2A2 | |
| Western Blot, Immunohistochemistry (Paraffin) | |
| Unconjugated | |
| Rabbit | |
| Mouse, Human, Rat | |
| O94973, P17427, P18484 | |
| 11772, 161, 81637 | |
| AP2A2 Fusion Protein Ag8442 | |
| Primary | |
| -20°C | |
| AP2A2 |
| 0.27 mg/mL | |
| Polyclonal | |
| Liquid | |
| RUO | |
| PBS with 50% glycerol and 0.1% sodium azide; pH 7.3 | |
| ADTAB, Alpha adaptin C, Alpha2 adaptin, AP 2 complex subunit alpha 2, AP2A2, CLAPA2, HIP 9, HIP9, Huntingtin yeast partner J, HYPJ, KIAA0899 | |
| Ap2a2 | |
| IgG | |
| Antigen Affinity Chromatography | |
| Antibody |
¿Detecta una oportunidad de mejora?Comparta una corrección de contenido
Corrección del contenido de un producto
Proporcione sus comentarios sobre el contenido del producto rellenando el siguiente formulario.
Título del producto